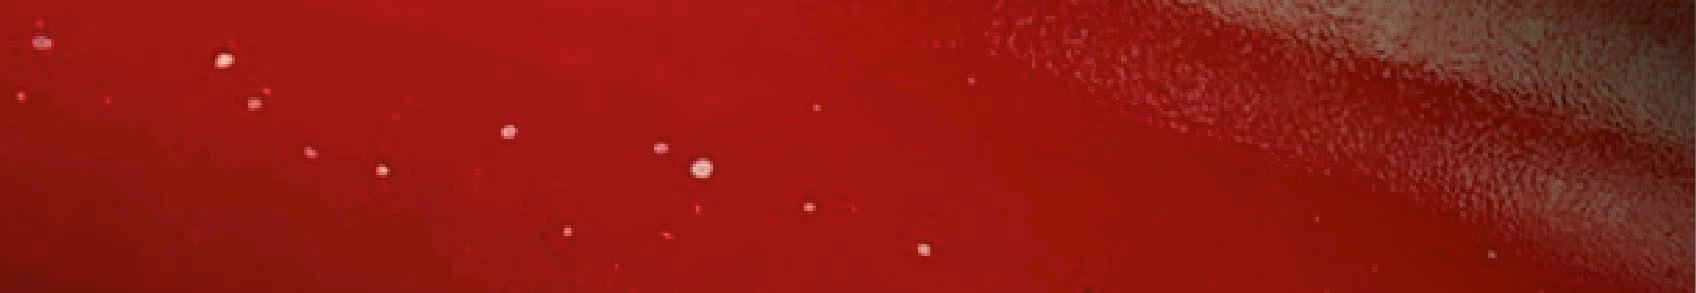

CABLES













The November issue of International Power Engineer is, as usual, heavily focused on renewables. The cover article, Pioneering Cables (page 12), looks at the expansion of leading cable company Nexans as well as the work it is doing to help oil and gas clients switch to renewables. The new UK government is working hard in this space too, with a renewables energy budget increase of 50% yearon-year, and a renewables auction round promising to deliver 131 clean energy projects powering the equivalent of 11 million homes.
These projects include the Hornsea 3 project off the Yorkshire coast and Green Volt, the largest floating offshore wind project in the world, This push ties in with the government’s ambitious plan to achieve 100% clean power by 2030. Readers with a particular interest in wind energy should consider attending the upcoming show Offshore Wind North East, a regional event that will feature many industry leading speakers and exhibitors – see page 53 for more details.
On the other side of the world, China's solar energy sector is currently delivering more usable energy per annum than the top seven oil and gas companies worldwide, according to a recent report from Bloomberg. Some rare good news for the environmental lobbyists.
The production of hydrogen also features strongly in this magazine with an interesting article from MIT on how to create cost effective green hydrogen (page 46). We also provide details of a liquid air Long Duration Energy Storage (LDES) system for storing renewables, such as hydrogen, on page 34.
Nicola Brittain Editor


Precise timekeeping to help utility substations improve
How cladding can help manage boiler
How corrosion resistance has shifted from protection to prevention
New technology that boosts drilling capacity for energy companies
How one energy storage solution provider promises to change the UK energy landscape
PUBLISHER
Jerry Ramsdale
EDITOR
Nicola Brittain nbrittain@setform.com
STAFF WRITER
Jake Holmes jholmes@setform.com
DESIGN
Dan Bennett, Jill Harris
HEAD OF MARKETING
Shona Hayes shayes@setform.com
HEAD OF PRODUCTION
Luke Wikner production@setform.com
BUSINESS MANAGER
John Abey +44 (0)207 062 2559
SALES MANAGER
Darren Ringer +44 (0)207 062 2566
ADVERTISEMENT EXECUTIVES
Paul Maher, Iain Fletcher, Peter King, Adam Croft
A guide to the emission of mercury in the
New innovations promise cost reductions in green hydrogen production
How an innovative sensor will advance the green transition
How HDVC control valves help to minimise losses
A guide to addressing potential safety concerns on windfarms
How one plant manufacturer helped a client to become energy self sufficient
A guide to mitigating the issue of unexploded ordnance
alternative fuel
Exploring ammonia and methanol regulations in the maritime industry
A show that promises to boost business in the region 54 European hydrogen week
This Belgium-based event will explore the future of hydrogen







Setform’s international magazine for engineers is published twice annually and distributed to senior engineers throughout the world. Other titles in the company portfolio focus on Process, Design, Transport, Oil & Gas, Energy and Mining.
The publishers do not sponsor or otherwise support any substance or service advertised or mentioned in this book; nor is the publisher responsible for the accuracy of any statement in this publication. ©2024. The entire content of this publication is protected by copyright, full details of which are available from the publishers. All rights reserved. No part of this publication may be reproduced, stored in a retrieval system, or transmitted in any form or by any means, electronic, mechanical, photocopying, recording or otherwise, without the prior permission of the copyright owner.
Setform Limited, 6, Brownlow Mews, London, WC1N 2LD, United Kingdom
+44 (0)207 253 2545


PIONEERING CABLES
A leader in sub-sea cables expands its capacity






ACTUATOR RETROFIT
How retrofitting actuators can help to generate green electricity
The Swedish capital Stockholm is currently benefitting from sustainable energy generation from the city’s largest combined heat and power plant Kraftvärmeverk 1 (KVV1), where 241 modern actuators from actuator specialist Auma have been installed.
The plant was originally built in 1976 for fossil fuels. In 2022, plant operator Stockholm Exergi initiated a large-scale retrofit project to modernise the CHPP, enabling operation with renewable fuels such as bio-oil.
Auma’s experienced retrofit experts helped Stockholm Exergi find the most suitable electric actuation solution for each application: SA and SQ actuators with AC 01.2 actuator controls, sometimes combined with GST and GS gearboxes or LE linear units, as well as SAR and SARV modulating actuators for more stringent control requirements.

The Auma service team took care of the entire project management: from a detailed analysis of the requirements, through the selection and sizing of suitable actuators from Auma’s broad actuator portfolio, to installation and commissioning on site.
Auma offers comprehensive retrofit services, helping plant designers and operators upgrade their existing plants with state-of-the-art, high-performance
valve actuation technology, according to the company. Examples include when a new control system is introduced, when new requirements for actuator diagnostics arise, or when manually operated valves need to be automated.
GLOBAL INDUSTRY INSIGHTS
SOCOMEC LAUNCHES ENERGY STORAGE DEVELOPMENT CENTRE
Global manufacturer of energy storage solutions Socomec has launched a multi-million-euro energy storage development centre near Strasbourg, France. The Energy Storage System (ESS) grid lab will develop technology for grid security, resilience, and reliability. With a highly modular and flexible testing environment, the facility can replicate different storage project conditions and installations via an on-site microgrid. The 500m2 facility will test the capabilities for a range of energy storage projects that would be impossible to test for safety if running off real world networks.
Flavien Martos, energy storage solutions specialist, Socomec (pictured right), said: “To support a clean transition and ensure, for example, that the electric vehicle charging infrastructure continues to roll out long-term, it’s critical we have the technology required to deliver it and ensure future grid security, flexibility, and reliability. By being able to replicate our customers’ grid scenarios we can run development and factory acceptance checks of the custom storage offerings we provide.”
The development centre has 15 employees on-site and is set to expand with a new customer showroom later this month.

The Auma retrofit service helps plant operators upgrade their existing plants with modern, high-performance valve actuation technology
GIGAHUB TO BOOST HYDROGEN PRODUCTION IN GERMANY
Electrolysis specialist Quest One, a subsidiary of Man Energy Solutions, has opened a new ‘gigahub’ for the serial and automated production of electrolysis stacks in Hamburg, Germany. At the launch, Quest One’s CEO Robin von Plettenberg described this as a ‘new phase’ in the ramp-up of the hydrogen economy.
The hydrogen technology specialist will use the site to start the serial and automated production of Proton Exchange Membrane (PEM) electrolysis stacks for the production of green hydrogen. PEM electrolysis is believed to be one of the most important processes for industrially scaled hydrogen production from renewable energies.
Man Energy Solutions called the series production an important step towards making green hydrogen available in large quantities and thus becoming a reliable alternative to fossil fuels.
PFEIFFER VACUUM LAUNCHES A HYDROGEN VACUUM AND LEAK DETECTION SOLUTION
Technology manufacturer, Pfeiffer Vacuum, recently launched a series of vacuum and leak detection solutions for the hydrogen and fuel cell sector. One of these, the OmniStar GSD 350, is a compact, portable benchtop device which permits gas analysis at atmospheric pressure. It enables fast, reliable and precise measurement of noncondensable gases, according to the company. The product uses mass spectrometer software PV MassSpec to provide qualitative and quantitative analyses. The product covers the mass ranges 1 to 100 amu, 1 to 200 amu and 1 to 300 amu making the OmniStar GSD 350 suitable for material characterisation tasks, such as hydrogen permeation testing through tank or sealing materials.
Pfeiffer has also launched the ASM 340, a versatile leak detector for hydrogen and helium. The product can be used for qualitative localisation of leaks as well as for quantitative integral or local testing.
The company’s mobile Leak Test Module offers a modular solution for leakage testing. Its individually configurable components make the module suitable for a wide range of leak-testing tasks using helium and hydrogen forming gas as tracer gases.

BGEN AWARDED HINKLEY POINT CONTRACT
UK engineering firm BGEN has been awarded a £84m project by GE Steam Power Systems to provide electrical and instrumentation solutions to the Hinkley Point C nuclear power station in Somerset. When complete, Hinkley Point C is expected to deliver 7% of the UK’s CO2-free energy for the next 60 years. The plant is projected to generate 3.2+ GW to the grid – enough energy to power six million homes, while saving nine million tons of CO2 emissions a year. GE Steam Power will supply the two conventional power islands for the contract, these include the Arabelle steam turbine, generator and other critical equipment. The Arabelle produces 2% more power output than a traditional configuration, has a 99.96% reliability rate and will be the largest ever to be built. Each power island is capable of producing 1,770 MW of electrical power.
BGEN’s remit includes the design, supply and installation of electrical and instrumentation packages for Unit 1 and Unit 2 turbine halls of the power plant. Standing at 50 metres high, each will house a large Arabelle steam turbines, along with a generator and other equipment.
BGEN will provide solutions to the Hinkley Point C nuclear power station
MAINTAINING INTEGRITY
How
multi-cable
and pipe transits ensure the integrity of wind turbine structures and substations
The offshore wind industry has seen remarkable growth in recent years, driven by the global transition toward renewable energy and the increasing demand for sustainable power solutions. As offshore wind farms expand in size and complexity, ensuring the safety, reliability, and efficiency of these installations becomes paramount. One critical aspect of offshore wind infrastructure that contributes to these objectives is the use of multi-cable and pipe transits. These components play a crucial role in maintaining the integrity of wind-turbine structures and substations.
FACTS – RHYL FLATS WIND FARM:
Rhyl Flats is a 25 turbine, 90 megawatt wind farm located in Liverpool Bay, approximately eight kilometres north east of Llandudno in North Wales. The wind farm produces enough clean energy a year to power 70,000 households, equivalent to cutting 1.7 million tonnes of CO2 emissions a year. The wind farm began producing power in December 2009.

THE ROLE OF MULTI-CABLE AND PIPE TRANSITS IN OFFSHORE WIND
Multi-cable and pipe transits are sealing systems designed to secure cables and pipes that pass through bulkheads, decks, and other structural boundaries in offshore wind installations. These transits are engineered to provide a tight seal around cables and pipes, preventing the ingress of water, gas, fire, and other potentially harmful elements. In the offshore wind industry, where installations are subjected to extreme weather conditions, corrosive saltwater, and the constant threat of fire, the importance of these sealing systems cannot be overstated.
One of the primary functions of multi-cable and pipe transits is to maintain the structural integrity of offshore wind installations. The harsh marine environment poses a significant challenge to the longevity

of wind turbines and substations. Multi-cable and pipe transits help mitigate these risks by providing a barrier that prevents the entry of corrosive elements, thereby extending the lifespan of the installation and reducing maintenance costs.
FIRE SAFETY AND RISK MITIGATION
Fire safety is another critical concern in offshore wind installations. A fire outbreak in an offshore wind turbine or substation can have catastrophic consequences, not only endangering the lives of personnel but also leading to significant financial losses and environmental damage. Multi-cable and pipe transits are designed to provide fire-rated sealing solutions, which means they can withstand exposure to high temperatures and flames for a specified duration. This fire resistance is crucial in preventing the spread of fire through cable and pipe penetrations, thereby containing
Robust multi cable and pipe transits ensure secure, weather-resistant seals in offshore wind installations and are vital for protecting critical infrastructure from harsh marine environments
In addition to fire protection, multi cable and pipe transits also offer resistance to gas and smoke

A round cable transit pallet securely stacked in a warehouse, ready for shipment or storage
the fire to its point of origin and allowing for more effective firefighting measures.
In addition to fire protection, multi cable and pipe transits also offer resistance to gas and smoke. In the event of a fire, smoke and toxic gases can spread rapidly through a wind installation, posing a serious risk to human health and complicating evacuation efforts. By sealing cable and pipe penetrations, these transits help contain the spread of smoke and gases, providing additional time for personnel to evacuate and for emergency response teams to take action.
ENHANCING OPERATIONAL EFFICIENCY
Beyond safety, multi cable and pipe transits contribute to the overall efficiency of offshore wind operations. Offshore wind farms require extensive cabling to connect turbines to substations and transport electricity to the shore. Multi-cable transits allow for the organised routing of multiple cables through a single penetration
point, optimising space and reducing the complexity of cable management. This not only streamlines the installation process but also simplifies maintenance and inspection activities, leading to reduced downtime and operational costs.
Moreover, the flexibility offered by multi-cable and pipe transits is a significant advantage in the dynamic offshore wind environment. As wind farms expand or undergo upgrades, the ability to add or remove cables and pipes without compromising the integrity of the sealing system is invaluable. Modern transit systems are designed with modularity in mind, allowing for easy reconfiguration to accommodate changes in cable or pipe arrangements.
ENVIRONMENTAL CONSIDERATIONS
The environmental impact of offshore wind installations is another factor driving the adoption of multi-cable and pipe transits. Offshore wind farms are typically located in ecologically sensitive areas, and any breach in the integrity of these structures can

lead to environmental contamination. The ingress of seawater or other contaminants through unsealed cable or pipe penetrations can result in leaks or spills, harming marine life and ecosystems. By providing a reliable barrier against environmental threats, multi-cable and pipe transits help minimise the environmental footprint of offshore wind projects, aligning with the industry’s commitment to sustainability.
CONCLUSION
As the offshore wind industry continues to grow and evolve, the importance of robust sealing solutions like multi-cable and pipe transits cannot be overlooked. These systems play a critical role in ensuring the safety, reliability, and efficiency of offshore wind installations, protecting against the harsh marine environment, enhancing fire safety, and optimising operational efficiency.
PRECISION POWER ANALYSIS
How a loss measuring system is ensuring that transmission companies can accurately review the amount of energy reaching their consumers
Transformers are a crucial part of electricity distribution and transmission networks, performing the important conversion steps between the very high voltage at which power is transmitted over long distances to intermediate voltages in local networks or lower voltages to households and commercial users.
Achieving this with minimal losses is a high priority for electricity distribution and transmission network operators, who only earn revenues on the power that is actually supplied to their end users.
Electrical equipment supplier Royal SMIT Transformers B.V. supplies large, high-voltage transformers to energy generation and energy transmission companies all over the world. It is responsible for phase-shift transformers and shunt reactors as well as developing, producing, selling and maintaining transformers rated from around 200 MVA up to 1,200 MVA in a voltage range up to 765 kV.
Every customer requirement is unique, and nearly every transformer is custom engineered to order. Being able to measure power losses accurately to make sure products comply with specifications is an important part of the process. Each of Royal SMIT’s test bays incorporates a three-phase transformer power-loss measuring system consisting of high-voltage reference capacitors, zero-flux current transformers, and a three-phase precision power analyser supplied by Yokogawa Test and Measurement.
When Royal SMIT decided to build a new test facility, the challenge was to design a stable and reliable environment in which measurement uncertainty forms a negligible component of measured losses. Part of the solution, based on experience with Yokogawa precision power analysers that have served Royal SMIT well in

the past, was to use Yokogawa’s newer WT5000 model.
The WT5000 Transformer Version’s accuracy of just ±0.008% at a power factor of one restricts measurement error to a negligible fraction of total measured losses. It also achieves the highest possible accuracy at power factors as low as 0.001.
One feature that contributes to the WT5000’s accuracy and long-term stability is a special aging treatment. First the instrument is optimised by calibration at 53 Hz at power factors of 1, 0.5, 0.05, 0.01 and 0.001. Additional calibration at up to 100 kHz ensures the required performance when measuring distorted waveforms that can be encountered when measuring no-load loss currents.
Other features include an intuitive user interface with the ability to define and use event triggers and custom computations.
The WT5000 Transformer Version
has helped Royal SMIT reduce measurement error significantly, with 12-month accuracy improved from ±0.01% to ±0.008%. The linearity of the WT5000 Transformer Version is also impressive, according to the company The newer product offers one effective input range covering values from 10% to 110%, as well as sampling 50 times faster than the WT3000 and providing resolution that is four times higher.
According to Steven Lauf, senior test engineer at Royal SMIT, the WT5000 has operated “completely trouble free, and the three measurement channels being operated in the test system hardly need to be adjusted at all, even though the instrument can be on for days at a time.”
The -WT5000 Precision Power Analyser – Transformer Version

FUTURE
Each project is designed to bespoke specifications


PIONEERING CABLES
A Norwegian cable company grows its capacity and proves its commitment to electrification, Nicola Brittain reports
Norway-based Nexans has just finished celebrating the launch of an expansion to its high voltage subsea cable plant in Halden, Norway. The company argues that this build is a demonstration of its commitment to electrifying the future.
The plant construction began in November 2021 and incorporates some of the most advanced cable production technology worldwide according to the company, meaning it can deliver subsea cables (primarily for wind turbines) of up to 525kV for HVDC and 420kV for HVAC.
A NEW TOWER
The 34,000 square metre expansion more than doubles the capacity of the plant for HVDC extruded cables, it also features a 152.89 metre tall second extrusion tower which will allow the plant to insulate four cables
simultaneously in addition to the two existing lines – the tower is currently Norway’s tallest building.
This build will help the group meet the increasing demand for electrification, especially in the American and European markets driven by a record project backlog, a €1.7 billion contract with Tennet, and a €1.43bn contract for the EuroAsia Interconnector project. This new strategic asset will also directly and indirectly create hundreds of jobs worldwide.
The tower was built at a difficult time, during lockdown, in which according to one of the factory managers, “suppliers were going bust, there were order bottlenecks and the world faced general global economic uncertainty.” He added, “we are very proud to have finished the build on time when facing such difficult economic conditions.”
THE COMPANY STREAMLINES CAPACITY
In recent times the company has streamlined its activities to focus on the supply of electric cables, accessories and associated services across the entire value chain from the power generation phase through power transmission and distribution to the end customer.
To date, the company has completed over 443 subsea interconnection projects representing 46GW of installed capacity or 10,680km of subsea cables. For offshore wind, Nexans has either manufactured or installed subsea export cables for 42 windfarms globally, representing 64.3GW of offshore wind capacity.
IPE attended the expansion launch and caught up with the leader of the company’s generation and transmission team and executive vice
president of Nexans Pascal Radue on the company’s aims for the future.
Redue who has a background in power generation, explained that the new tower was a response to a big drive among its traditional customers to decarbonise oil and gas fields and that Nexans were helping partners do this in “the quickest and most sustainable way possible.”
“We want to help the world move from fossil fuels to renewable energy. But wind doesn’t give the same output to the grid as a traditional generator. The challenges are that when the wind doesn’t blow or the sun doesn’t shine need we will need to access stored energy or transmit it from a place where there are these resources. These are two key parts to the renewable energy puzzle and cables can help to solve them.”
STANDARDS NEEDED
Redue explains that there is currently a capacity constraint within the sector and that this would be helped enormously by creating an industry standard around these advanced cables and their transmission. “Our projects are currently extremely bespoke meaning that their manufacture is incredibly time consuming,” he says.
Redue continues, “the real game in this industry, is that we are able to deliver. In order to maintain the speed of the energy transition as well as groundbreaking developments there are a lot of processes required to ensure

The new plant can deliver cables of up to 525kV for HVDC and 420kV for HVAC
that there are no surprises. The industry is all about securing execution – from the drawing board to reality.”
The company is supporting sustainability in other ways too, and recently set up a foundation to support sustainable initiatives and bring access and energy to disadvantaged communities worldwide. The group is recognised on the CDP Climate Change A list as a global leader on climate action and is committed to Net-Zero emissions by 2050, aligned with the sciencebased targets initiative.
The company also recently ramped up capacity by acquiring La Trivaneta Cavi, a European leader in medium

and low-voltage cables. The company primarily manufacturers low voltage cables for building, infrastructure fire-retardant cable systems and renewable energy applications across 30 countries.
Nexans CEO Christoper Guerin says of the acquisition: “This is fully in line with our vision of Nexans as a global electrification pure player. This move significantly strengthens our presence in the electrification pure player segment.”



MEASURING HYDROGEN PURITY
The product provides reliable, stable instrumentation for real-time H2 fraction determination
The production and use of hydrogen is expected to increase dramatically in the coming years as the search for low-carbon alternatives to fossil fuels gathers pace. Hydrogen can be produced from renewable energy and water and does not produce CO2 on combustion, but its properties vary significantly enough from those of natural gas such that it forces new considerations on measurement technology.
There are many different norms for hydrogen quality and at least as many requirements from end-users that must be respected.. These can range from ultra-pure hydrogen for hydrogen fuel cells (from e.g. 99.97%, ISO 14687-2), to combustion applications, where lower qualities (<98%) can easily suffice.
To ensure that purity requirements are met, hydrogen quality is measured during production, transport and before end-use. For the most stringent requirements, the hydrogen fraction as well as the fractions of all impurities must be determined. In this case the individual gas components must be measured directly, for example using a gas chromatograph.
For less exacting measurement tasks, such as the determination of hydrogen purities on the order of 98% or even 99.5%, or as an online monitor of hydrogen purity and gas quality, correlative measuring technologies can be an excellent alternative. Correlative measurements function by equating the measured quantity (e.g. thermal conductivity) to, for example, the hydrogen fraction via calibration. Measuring instruments based on these technologies are significantly less
expensive (CAPEX and OPEX), require less maintenance, are more robust and can easily be distributed and integrated into an existing infrastructure.
The physical properties of hydrogen are very different to virtually every other gas, which makes correlative measuring instruments particularly useful for hydrogen purity applications. Such instruments are typically based on measurements of thermal conductivity, speed of sound, or density of the gas mixture. Measuring instruments based on thermal conductivity, such as the gasQS static from Mems AG, can easily be configured to measure thermal conductivity in the range of interest, regardless of whether this is 99.5-100%, 98-100% or even 0-2% hydrogen. It is also precise, with excellent long-term stability, and is temperature (-20°C… +80°C) and pressure compensated (0barg….15barg).

The gasQS static from Mems AG is an example of a correlative measuring instrument based on thermal conductivity measurements
One property of correlative measuring instruments with a single measurand is the requirement that the measured gas mixture must be quasi-binary and set at calibration, otherwise small errors in the measurements can result. However, for hydrogen purity applications these errors are reduced considerably: the thermal conductivity of hydrogen is so much higher than that of other gases (other than helium) that changing the ratio of impurities does not significantly impact the thermal conductivity of the gas mixture and hence the measurement accuracy.
The measurement challenges linked to the advancing hydrogen economy are many and varied, with no one-size-fits-all solution. Correlative measuring instruments are characterised by simplicity, cost-effectiveness and robustness and have the potential to play a significant role in hydrogen purity measuring solutions.
For more information visit: www.mems.ch

A simple schematic of the thermal conductivities of a range of gases at room temperature and pressure






Certas supplied, installed and helps maintain the lubricant system for its client
A COMPLETE OVERHAUL
How one lubricant specialist helped transform a large UK power facility
In seeking to maintain its critical infrastructure for the national grid, a major power generation facility in the UK engaged Certas Lubricant Solutions to supply, install, and maintain the lubricant system for its synchronous compensators. These synchronous compensators play an essential role in stabilising the grid by providing voltage and frequency balance through inertia. Maintaining optimal performance of such machines is crucial for electricity distribution stability.
This case study details the collaboration between Certas Lubricant Solutions and the power facility, exploring the challenges
faced, solutions provided, and the successful completion of the lubricant replacement project.
INITIAL CONTACT
The initial contact came through Castrol, which was approached by the power plant to procure 42KL of turbine lubricant oil, specifically Castrol Perfecto X 46. Given that Castrol does not supply directly, they recommended Certas Lubricant Solutions as their official ambassador supplier in the UK.
Certas promptly established communication with the customer, introducing the company’s services and capabilities, leading to an on-
site meeting with the plant manager and rotating plant engineers. It was revealed that the facility had recently performed a Remaining Useful Life Evaluation Routine (RULER) test, which indicated that the turbine oils used in the two synchronous compensators were nearing the end of their serviceable life.
Given the criticality of the synchronous compensators in stabilising grid frequency, the plant needed to act swiftly. The facility was scheduled for a two-week shutdown in four weeks, providing a short but manageable window to replace the lubricants. The initial request was for lubricant supply, but the opportunity
expanded when Certas also offered to provide all the necessary equipment and manpower for the removal of old oil, tank cleaning, and the installation of new oil.
PREPARATION AND PLANNING
The project required meticulous planning owing to the time-sensitive nature of the work and the potential risks involved, particularly given that the oil tanks qualified as confined spaces. Certas arranged all aspects of the project, from waste oil tankers to safety preparations, including Risk Assessment and Method Statement (RAMS) documentation.
Certas coordinated the delivery schedule with Castrol to ensure timely arrival of the new oil from Belgium, while the customer arranged for a rescue team to assist with confined space work.
The project plan was divided into several stages:
1. Waste oil removal: Certas partnered with Utility Oils, a registered waste carrier, to handle the removal and disposal of the used oil in compliance with UK environmental regulations.
2. Tank cleaning: The Certas team entered the empty tanks to remove any residual oil and debris.
3. New oil installation: Castrol delivered the new oil, which was pumped into the freshly cleaned tanks. Certas utilised filtration units to ensure a contaminant-free installation.
EXECUTION
Day 1: Waste oil removal and tank cleaning
On the first day, a waste oil tanker from Utility Oils arrived on-site to remove the used oil from the first 21KL lube oil tank. The used oil was drained via the bottom drain point, and the top entry cover of the tank was removed to allow proper ventilation.
Once the tank was emptied, a certified rescue team was on standby while a Certas technician entered the confined space to manually clean the tank. This step involved removing residue and debris left inside the tank, a process crucial to ensuring the quality of the new lubricant once installed.

Day 2: Repeating the process on the second tank
The same procedure was followed on the second day for the second synchronous compensator’s 21KL tank. The used oil was drained, and the tank was cleaned in preparation for the new lubricant.
Day 3: Delivery and installation of new oil
On the third day, two oil tankers delivered the new Castrol Perfecto X 46 directly from Belgium. Each tanker carried 21KL of oil, which was installed into the respective tanks. The oil was pumped in through the top entry orifice, while filtration units were used to prevent contamination. Once the tanks were filled, Certas conducted final inspections to ensure proper installation and system functionality.
CHALLENGES AND SOLUTIONS
A key challenge was the coordination of various teams - Certas personnel, the waste management partner, the Castrol delivery team, and the customer’s onsite rescue team - all while adhering to the tight timeline dictated by the scheduled plant shutdown.
Additionally, confined space work posed inherent risks, requiring thorough planning, safety measures, and immediate problem-solving to ensure the technicians’ safety during tank cleaning operations.
Certas Lubricant Solutions successfully managed these challenges through precise planning and collaboration.
CONCLUSION AND CUSTOMER FEEDBACK
Customer feedback following the oil replacement and system testing was overwhelmingly positive, according to the company.
One notable outcome of the project was the cleanliness of the new turbine oil. Certas advised the customer to monitor for an initial increase in particulates during early oil sampling. This proactive communication helped manage expectations and ensure customer satisfaction.
Through this project, Certas Lubricant Solutions demonstrated that it was able to handle complex, largescale lubricant supply and installation projects, which it argues reinforces its reputation as a trusted partner in the energy sector.
Certas coordinated the delivery schedule with Castrol to ensure the oil’s timely delivery
MICROGRID UPDATE
Ageothermal research project in the Netherlands has been able to continue vital research toward the energy transition following the installation of an ultra-low emission microgrid from global energy solutions provider, Aggreko.
The project is led by Dutch-state backed Energie Beheer Nederland (EBN), based in Utrecht, and involves researching several onshore wells to identify whether they are suitable for the extraction of geothermal energy. If successful, it has the potential to be a reliable and constant source of lowcarbon and renewable heat that is not dependent on weather conditions.
EBN needed a solution that could provide up to 2600 kW peak power for its drilling rig while meeting ambitious emissions targets that go beyond the Dutch government’s stringent regulations. A conventional temporary power solution would have been unable to meet such stipulations, forcing the project to cease operations.
As a specialist in power and temperature control, Aggreko presented several emissions reduction alternatives for EBN to review. The

A new project investigates the possibility of geothermal energy extraction from onshore wells

final microgrid solution consisted of Aggreko’s latest PowerMX2 twin engine Stage V generator on a loadon-demand application alongside a battery. This solution provided peak power for the drill, while reducing emissions during lower loads or rig idle.
As well as hitting the targets set out by EBN, the sustainable Aggreko solution was also able to provide a reduction in NOx emissions of up to 90%. Siebe Viersen, senior drilling supervisor at EBN says: “This project allows us to assess the possibilities of geothermal heat, and therefore increase the chance of successful projects to heat homes and buildings in the Netherlands. This is part of our commitment to sustainability, something shared by Aggreko which makes them a solid partner for our exciting research.”
Loesje van Dongen, sector account specialist at Aggreko adds: “Unlike other renewables such as solar and wind, geothermal energy is not weather dependent, making it a sustainable and reliable commodity, and incredibly important for creating
a sustainable energy future – something we are heavily invested in at Aggreko. This project is a live example of how we are supporting the energy transition through our sustainability framework called Energising Change. The framework sets out a series of initiatives and investments which will enable regions, and organisations, to scale up their approach to a renewable energy future.”
Aggreko’s sustainability framework helps support companies on their decarbonisation journey by providing greener upgrades through sustainable technologies and techniques that help to lower carbon emissions and deliver fuel savings. Aggreko claims that this Netherlands project demonstrates how the company is integrating its investment into the latest technologies with innovative thinking to achieve ultra-low emissions and an efficient solution.
A Netherlands-based research project is using a microgrid from Aggreko
energy potential






HYDROGEN SAFETY
A look at safety risks and solutions around hydrogen manufacturing
Capitalising on the immense benefits of hydrogen as a green energy source requires several processes including its production, storage, transportation and usage. Each of these stages required to realise the advantages of hydrogen energy also pose safety challenges that must be addressed in accordance with the unique properties of hydrogen and hydrogen production.
PROCESS HAZARD ANALYSIS
For any new or existing hydrogen production applications, a Process Hazard Analysis (PHA) can help assess any potential risks associated with the various stages of hydrogen manufacturing and usage. At the conclusion of the PHA, a risk assessment report will be created and may identify the following at-risk areas and their potential solutions:
OVERPRESSURE HAZARDS
Pressurised hydrogen exists throughout the creation, storage, transport and usage of hydrogen. Without a reliable means of pressure relief, a vessel can fracture and even result in a pressure-related explosion.
To relieve excess pressure and prevent catastrophic failure of the containment system, two methods of pressure relief are used: pressure relief valves (PRVs) and rupture discs. PRVs gently open and close as pressure fluctuates, while rupture discs ‘burst’ when pressure reaches a certain undesirable level.
While both devices provide reliable pressure relief, it’s a common practice to use both PRVs and rupture discs in tandem with one another. For example, by installing a rupture disc upstream of a PRV, unwanted leakage of valuable product is avoided, as the



hydrogen will only reach the PRV if the rupture disc opens.
FIRE HAZARDS
Because hydrogen fires are invisible, traditional fire detection methods that rely on visible flames or smoke are ineffective and unreliable. That’s why flame detectors with infrared technology are recommended to identify the thermal energy produced by hydrogen fires allowing for quick emergency response, mitigation measures and system shutdown.
Some flame detectors also include an on-board camera that visualises the exact location of the hydrogen flame on a connected monitor to protect nearby workers and direct safety personnel.
EXPLOSION HAZARDS
Owing to the wide flammability range and low ignition energy of hydrogen gas, explosive atmospheres are common in these applications. Explosion vents are a commonly used protection strategy that, like rupture discs, open when a specific pressure is reached to safely relieve the pressure and redirect flames away from people and other critical areas.























‘Flameless’ devices may also be used to make explosion venting of indoor applications possible as they suppress the flames while allowing pressure to pass through.
CONCLUSION
The various stages of hydrogen production each involve their own unique equipment and processes, and it is therefore essential for managers to partner with an expert in hydrogen safety who understands all the potential hazards and solutions.
Conducting a PHA is almost always a necessary first step, it will help document any possible risks and provide a better understanding of areas that should be further investigated as well as those that are safe from the aforementioned hazards. The safety solutions provider should then work with the client to methodically reduce the risk of each of those hazard areas with recommended process improvements or required safety systems.
Reliable pressure relief and fire detection prevent fractures and undetected fires
















































SOLAR SOLUTION
A new analyser helps maintain continuous testing at large solar installations
Installation and maintenance engineers working on solar photovoltaic arrays and farms need to be able to test their output on a continual basis to ensure consistency.
Analysers have traditionally struggled to obtain IV curve tracings for large solar installations owing to high capacitance levels meaning they can’t record continuously without overheating. A new product from global technology provider Fluke, the Solmetric PVA-1500HE2 PV Analyzer and I-V Curve Tracer has been designed for use throughout the day without any interruptions.
With this product, in conjuntion with the I-V Curve Tracer, solar energy engineers, energy consultants and field technicians are provided with access to a tool that boosts on-site productivity when verifying PV performance. The device minimises the time required for each testing cycle by delivering unprecedented measurement throughput speeds and provides a much higher return on investment than other PV testers by delivering better levels of stability and accuracy, according to the company.
The Fluke Solmetric PV product provides I-V curve tracing for largescale solar installations. Similar products can often struggle to obtain accurate readings owing to high capacitance levels and are incapable of recording data continuously without overheating. Having to disconnect an I-V curve tracer until it cools down is disruptive in an environment where time is crucial but the this product eliminates this problem because it can be used throughout the day without interruption.

THE FLUKE SOLMETRIC PVA-1500 SERIES KITS
Fluke has bundled the new PV product into several kits. They are the first to combine the Solmetric product with such Fluke devices as the TiS75+ thermal camera, the 393 FC Solar Clamp Meter and 87V Industrial Multimeter, as well as the 1537 Insulation Resistance Tester. The company also offers a range of training packages for getting the most out of the the product and associated kits while addressing the shortage of skilled workers in PV installation testing.
The PV product has been designed for use throughout the day
Will White, Fluke solar application specialist, says: “The Solmetric name is widely respected around the world and bringing these high-quality products into the Fluke family means we now have tools in our portfolio that can test the entire solar sector. We believe that this is the only I-V curve tracer in the world that can offer users such impressive levels of performance, efficiency, throughput and reliability.”
For more information visit: www.fluke.com

Fluke has bundled the Solmetric PVA-1500HE2 PV Analyzer into kits containing devices such as the TiS75+ thermal camera































PRECISE TIMEKEEPING
Here we explore how precise timekeeping can help utility substations to improve fault location, and event reconstruction in their grids

Orion is a communication and automation processor that can connect to most substations
Precise timekeeping is fundamental to the function of the power grid and is used in many applications to improve reliability, reduce costs, predict and prevent faults, and check the operation of devices.
As such, utilities are continuously seeking ever greater precision. Luckily, advancements in satellite clock design and programming can help provide this. Currently, the accuracy is pushing towards a margin of plus or minus 20 nanoseconds.
HIGHLY ACCURATE SATELLITE CLOCKS
Satellite clocks work by connecting with orbiting satellites that maintain precise time using highly accurate atomic clocks. At the substation, the satellite clock receives time from the satellites in orbit. Utilising advanced algorithms, it then accounts for external factors to provide an accurate time.
To improve the speed of connection and accuracy, some clocks provide multi-constellation support, which provides the ability to lock into any available satellites orbiting the planet. The satellites include GPS, maintained by the US but used globally by the European Union’s global navigation satellite system GALILEO; China’s BEIDOU satellite navigation system; and Russia’s GLONASS global navigation satellite system.
Companies like NovaTech continue to invest in research and development to achieve even incremental improvements in clock accuracy in the sub-millisecond range.
The company’s flagship product, Orion, is a communication and automation processor that can connect to nearly any substation device in its native protocol, perform advanced math and logic, and securely present the source or calculated data to any number of clients in their own protocol.
“While any satellite clock can access satellites as a time source, the hardware and software within the satellite clock can make it more precise and accurate,” says Nathan Irvin, product manager of networking products at NovaTech Automation.
The latest release is the Kronos Series 3. This satellite clock provides
The
multi-constellation support and includes several upgraded features including antenna-cable delay compensation.
The Series 3 offers increased output flexibility for syncing devices with their optimal mechanisms, it also supports both traditional legacy formats and the latest technologies, such as Ethernet over fiber.
In addition, the product supports PTP, NTP, and SNTP. Common legacy formats also supported include modulated and unmodulated IRIG-B over twisted pair, coax, or fiber; and PPS or PPM signals as well as Parallel Redundancy Protocol (PRP) and the High-availability Seamless Redundancy (HSR) within an ethernet network.
The net results of these upgrades are more precise time with submillisecond accuracy.
Series 3 offers increased output flexibility for syncing devices with their optimal mechanisms
H2-content? Calorific value? Z-Factor? H2-purity?

Using our gasQS™ technology you can determine numerous gas properties with high precision and within shortest time.
Suitable for hydrogen shares up to 100 %
Fast measurement, short response time mems.ch
OIML R140 CVDD Class B compliant device
Robust with low maintenance, no carrier gas




Precision
timekeeping plays a critical role in the operation and efficiency of the power grid







UTILITIES BENEFIT
According to Irvin, there are many applications in the power grid that can benefit from more precise timekeeping.
- MULTI-RATE BILLING
To get better utilisation of the grid, power utilities often charge different prices at different times of the day. The revenue meters of utility and consumer as well as the machines and processes at the user’s site need a common time-base.
“Although this application does not require exceptional time accuracy, it can benefit utilities that implement a multi-rate billing structure,” says Irvin. “To ensure they are charging the end customer accurately, they need to have a precise time source to know when they should switch the rates.”
- EVENT RECONSTRUCTION
Events in the power grid need a spatial-temporal frame of reference (what happened where and when) so that cause and effect can be correctly understood.

“If some devices have a less accurate time source than others, then manual adjustments are required to properly reconstruct the events,” says Irvin. “Synchronising the devices in the network with a satellite clock eliminates a lot of this type of work.”
- POWER-FLOW MONITORING
The phase component of the socalled synchrophasors can be used to estimate the power flow and the stability of a power grid. The computation of synchrophasors is only possible if all the phasor measurement units (PMUs) use a common time base.
- TRAVELING WAVE-BASED FAULT LOCATION
The location of faults can be accomplished by precisely time tagging wavefronts. Faults on the power transmission system cause transients that propagate along the transmission line as waves. Each wave is a composite of several frequencies, ranging from a few kilohertz to several megahertz, having a fastrising front and a slower decaying tail.

- INTEGRATION OF RENEWABLE ENERGY RESOURCES
To connect to the national grid, the electrical energy from solar panels, wind turbines, or batteries is passed through inverters or power electronic converters. These devices convert the DC (direct current) output from the sources into AC (alternating current) suitable for transmission and distribution on the grid. In order to integrate renewable energy into the grid effectively, it must be synchronised with the existing grid frequency.
For utilities, precision timekeeping plays a critical role in the operation and efficiency of the power grid, emphasising the necessity for exact time synchronisation across devices to enhance reliability, minimise costs, and facilitate fault prediction and prevention.







CLADDING BOOSTS EFFICIENCY
How cladding can help manage boiler corrosion
In waste-to-energy (WtE) plants, operational efficiency and minimal downtime are crucial for both environmental and financial reasons. A recent case study from Turin, Italy, demonstrates how innovative technology can significantly improve plant performance and extend maintenance intervals.
THE CHALLENGE
The WtE plant in Turin, commissioned in 2014, faced a common problem: corrosion of boiler pressure parts. After several years of operation, water wall pressure part metal wastage was identified in the second pass of the boiler. The plant needed a solution that would protect the carbon steel tubes without causing extended outages or delays in their turnaround schedule.
FINDING A SOLUTION: HVTS CLADDING
High Velocity Thermal Spray cladding, provided by IGS, emerged as the preferred solution. Unlike traditional weld overlay methods, HVTS is not a welding process and doesn’t require the same rigorous approvals. This meant the plant could proceed with its planned outage without delays.
In 2019, IGS Europe was contracted on an emergency basis to apply their proprietary HVTS alloy cladding to a 159m2 area in the second pass of the boiler. The application covered four water walls, including the division wall, providing a protective barrier against degradation.
UNEXPECTED CHALLENGES AND QUICK SOLUTIONS
During a follow-up inspection in 2020, while the HVTS cladding was found to be in good condition, the plant identified degradation in the unprotected pendant screens in the same area. IGS quickly mobilised to protect these hanging panels, according to the company, This

demonstrated the flexibility and rapid response capabilities of the HVTS solution.
IMPRESSIVE RESULTS
The implementation of HVTS cladding, along with other strategic measures, led to significant improvements in the plant’s performance between 2019 and 2023:
1. Extended maintenance cycles
The interval between turnarounds increased from 12 to 18 months, reducing downtime and enhancing operational continuity.
2. Improved plant availability
Overall plant availability rose from 88% to 93%, representing a crucial 5% increase in operational capacity.
3. Cost efficiency
Despite inflationary pressures, maintenance costs decreased, contributing to improved financial performance.
4. Increased waste processing
The 5% boost in availability translated to an additional 18 days of operation
annually, enabling the facility to process an extra 10,000 tons of waste through the boiler.
This case study highlights the potential of HVTS cladding as a preventative maintenance solution in the power industry. By protecting critical components from corrosion and degradation, HVTS technology allows plants to optimise boiler performance, extend operational periods between planned maintenance interventions, and enhance overall efficiency.
In conclusion, the Turin case study serves as a compelling example of how targeted technological interventions can yield significant improvements in plant performance. The rapid application of HVTS cladding, compared with the timeconsuming process and approval of weld overlay, proved crucial in minimising downtime and maximising operational efficiency.
High emissivity coating was applied to refractory lining

PIB-based sealants offer significant advantages over conventional sealing systems

PIB-based
LENGTHENING LIFESPANS
How corrosion resistance has shifted from protection to prevention
In the ongoing battle against corrosion and asset integrity, the desire to extend asset lifespan has shifted towards prevention rather than mere protection. Traditional sealants and sealing method complexity and volatility often lead to disputes over responsibility and quality compromises. However, the growth in use and proven success of polyisobutene (PIB) sealants, are efficient and safer to apply while reducing maintenance needs over an asset’s lifetime.
A GAME-CHANGER
PIB-based sealants offer significant advantages over conventional sealing systems. These PIB-based sealants remain in a viscous state throughout their lifetime, maintaining fluidity even at temperatures below -60°C
(-76°F). This unique property allows them to:
1. Provide immediate and constant surface adhesion, creating a selfadhering effect
2. Form an instant barrier against oxygen and water
3. Adapt to thermal expansions, contractions, and asset movements
4. Penetrate surface pores effectively, ensuring lasting encapsulation from the environment
One of the most significant benefits of PIB-based sealants is their simplified application process as well as the following:
1. Minimal surface preparation/ cleanliness: Only removing loose existing debris, oil, or grease from the substrate.
2. Reduced inspection points: Fewer steps are required to achieve necessary surface cleanliness and preparation for sealing.
3. Simplified equipment: Cold applied by hand and hand tools like scissors, without the need for harmful primers.
4. No dry times or shutdown requirements: Application can be done without interrupting operations, and service can start on new construction immediately after application.
sealing technologies offer an ideal solution for protecting LNG infrastructure
These factors contribute to reduced labour costs, as the application process doesn’t require highlyskilled workers with intense training, complex equipment, and intense inspection before, during, or after the application process.
MEETING GLOBAL ENERGY DEMANDS: THE GROWING LNG MARKET
As the world seeks greener energy solutions to meet global demands and reduce carbon footprints, the liquefied natural gas (LNG) market is experiencing significant growth. LNG is considered a cleaner alternative to coal and oil, producing fewer greenhouse gas emissions during combustion. According to the International Energy Agency (IEA), global LNG trade has a growth of 20% between 2021 and 2025, reaching 585 billion cubic metres (bcm) [1]. This growth is driven by increasing demand in Asia, particularly China and India, as well as emerging markets in Southeast Asia and South America. The LNG industry requires extensive infrastructure, including liquefaction plants, storage tanks, and transportation vessels. All these assets are susceptible to water penetration, leading to eventual corrosion and premature insulating material/ system breakdown, due to exposure to harsh environments and extreme temperatures. PIB-based sealing technologies offer an ideal solution for protecting LNG infrastructure:
1. Cold resistance: Maintain effectiveness even at cryogenic temperatures associated with LNG (-162°C or -260°F).
2. Flexibility: Adapt to the thermal cycling and movements of LNG storage and transportation systems.
3. Easy application and maintenance: Reduce downtime, time to commission, and costs associated with insulation and corrosion protection in LNG facilities.
4. Environmental friendliness: Align with the industry’s goal of reducing overall environmental impact, being non-hazardous to humans and the environment.

PIB-sealing technology is an excellent solution for the LNG market, particularly as a vapour barrier. Given the inherit properties of the sealant, the proven performance to be a complete barrier to water and oxygen, and the ability to adhere to various substrates with minimal surface preparation and need for stringent surface cleanliness, products like Stopaq InsulWrap have been chosen to be applied overtop of cryogenic insulation. Stopaq InsulWrap is used to protect the insulation from moisture penetration to allow full effectiveness of insulation over time, but to also reduce risk of corrosion under insulation (CUI), which is often difficult to detect due to the visual inability to inspect under a multi-layer system of coating, insulation and cladding. The easy to apply wraparound system self-adheres without the need for primers, specific optimal temperatures or strapping to various types of insulation such as aerogel, mineral wool and foam glass. The self adhering abilities also provide the benefit of self amalgamation providing a seamless seal throughout the coating and sealing application area.
FUTURE OUTLOOK
As industries evolve to meet growing energy demands while reducing environmental impact, embracing effective, safer and easy to apply
technologies becomes imperative to the success and growth of the future energy market. PIB-based sealants offer a superior solution for asset integrity and protection in various sectors, including the rapidly expanding LNG market for not only corrosion under insulation protection but also for its vapour barrier capabilities through products like Stopaq InsulWrap. Their unique adhesion properties, ease of application, and impenetrable water and oxygen inherit benefits make them extremely beneficial for protecting vital infrastructure in the energy sector.
By adopting these advanced sealant technologies, companies can extend asset lifespans, reduce commissioning times on new build projects, reduce maintenance costs, and contribute to overall emission reductions. As the global energy landscape shifts towards cleaner alternatives, PIBbased sealants are well-positioned to play a crucial role in ensuring the longevity and integrity of critical energy infrastructure.
For more information visit: www.sealforlife.com References:
PIB-based sealants offer significant advantages over conventional sealing systems
BOOSTING ENGINE EFFICIENCY
New technology boosts capacity of specialist drilling techniques to produce complex components for use in the energy sector



Engineering solutions provider ELE Advanced Technologies has invested over half a million pounds in new technology following a major contract award.
Its investment of £700,000 in three brand-new Fast Hole Drill electrical discharge machines follows the company’s appointment by a global technology powerhouse located in Canada to provide complex components for use in the energy sector.
The new technology will enable ELE, a company that works with some of the biggest original equipment manufacturers in the world, to boost its capacity to undertake specialist drilling techniques to produce complex cooling holes for engine components that improve engine efficiency. Investment in the latest technology is central to how the business leads in its sectors for providing innovative engineering solutions says CEO David Stanley: “Our customers most often come to us when they are facing a
complex engineering challenge or have a performance target that they need to achieve.
“Offering a wide range of advanced technologies, combined with the technical capabilities of a highly skilled team applying a ‘can do’ attitude, enables us to help make the impossible possible,” he adds.
Installation of the new machines is the latest in a series of investments by the engineering business, which in 2023 invested £2 million when relocating to a larger 5,000 sqm manufacturing facility.
Employing more than 130 from its new facility in Nelson, Lancashire, the business provides engineering solutions in the aerospace, power generation and automotive sectors for an international customer base, with 75% of components manufactured going into Europe.
ABOUT ELE
ELE Advanced Technologies has provided solutions to engineering challenges for 70 years. Initially it was established to supply compressor blades to Rolls-Royce but the business has expanded to supply complex turbine components on a global scale.
Through industry expertise, collaboration and technical development, the company provides solutions for the aerospace, power and automotive market.
The company claims that its unique approach to supply-chain management, relationship building and sustainability enables delivery of ideas, capability and innovation.
The image shows one of the new machines in position prior to being commissioned and operational

LIQUID AIR
How one energy storage solution promises to change the energy landscape
of the UK
The UK Infrastructure Bank (UKIB) has committed £300 million for investment in the first commercial-scale liquid air energy storage (LAES) plant in the UK, to be run by pioneering energy storage company Highview Power. British energy and services company Centrica has also partnered with Rio Tinto, Goldman Sachs, KIRKBI and Mosaic Capital to raise funding for the LAES.
Based in Carrington, Manchester the plant will be one of the world’s largest long-duration energy storage facilities, according to the company. The site will afford a capacity of 300MWh and an output power of 50MWs per hour for six hours. It is due for completion in early 2026 with full roll-out expected for 2035 in line with the National Grid’s aims for 2GW LAES by the same time. Highview Power claims it will meet nearly 20% of the UK’s energy storage needs and last for 40 years.
The UK economy will benefit too since £9 billion will be poured into UK infrastructure over the next 10 years. The company anticipates that the project will ultimately create around 6,000 jobs, while over the short term, the construction and supply chain element of the project will create approximately 700 new jobs. The company also claims that the project will lead to improved energy security and reduced bills for households thereby strengthening the UK economy.

THE LAES EXPLAINED
Three main components make up Highview Power’s LAES: a charging device which utilises unused electricity to power an industrial liquefier producing liquid air; an energy store where the liquid air is held in an insulated tank; and a power recovery unit where the gasified liquid air is used to drive a turbine and generate electricity.
Renewable energy can be stored in the LAES for several weeks, an improvement on the battery technology currently being used across key grid locations at scale. Eventually, the solution promises to help provide stability to the national grid when using solar, wind and other renewable sources. The system will enable energy from renewables to be as responsive and flexible as fossil fuel energy, allowing the national grid to fully transition to green energy long term.
HOW IT WORKS
Firstly, in a process called the clawed cycle, air is cleaned, dried and refrigerated through a series of compression and expansion stages until it liquifies.
The liquified air is then stored in insulated tanks. When power is required, the liquid air is drawn from the tanks, pumped to high pressure then reheated
The Highview Power LAES storage facility
Richard Butland, CEO
and expanded. The gas created is used to power a turbine, creating clean electricity. No fuel is required in this process.
Waste cold from this process is captured by the cold store and later recycled to enhance liquification efficiency. In addition, the thermal store captures waste heat from the recharge in the thermal store, thereby increasing operational efficiency.
Highview Power’s LAES allows for a clean energy supply all year round and can meet energy demands on a reactive basis. This solution is not limited by geographical requirements, meaning it can supply clean energy across the country.
Chris O’Shea, group chief executive, Centrica said: “The energy transition is an opportunity that is likely to transform lives across the UK, it will create new jobs and reduce energy costs for households. But with a changing energy mix, and more intermittency from renewables, we have to explore new, innovative ways to store energy so that our customers have electricity available when the wind doesn’t blow and the sun doesn’t shine. Low carbon storage is an essential part of the solution.”
Highview Power’s LAES allows for a clean energy supply all year round and can meet energy demands on a reactive basis
FURTHER DEVELOPMENTS
Highview Power will not stop with the Carrington facility; it is also planning four large-scale 2.5GWh facilities, requiring a total estimated investment of £3bn. A fast rollout across the UK will be possible owing to the strategic sites picked for these facilities, aligning with UK LDES support mechanisms. This will help with National Grid ESO’s future energy scenario plans.
Richard Butland, co-founder and CEO of Highview Power says: “There is no energy transition without storage. The UK’s investment in world-leading offshore wind and renewables requires a national long-duration energy storage programme to capture excess wind and support the grid’s transformation.”
Julian Leslie, director and chief engineer of National Grid ESO says: “Integrating long-duration energy storage into the grid is going to be vital to delivering the UK’s long-term energy strategy. Our recent future energy scenarios report shows that 4GW of liquid air storage will be required over the coming decades. Highview’s plans are welcomed to support this target and help us on the journey to a 100% zero-carbon electricity system.”
This project demonstrates the UKIB’s commitment to investing in technologies that are critical for the net zero transition as well as supporting the UK’s regional and local economic growth.

ENSURE HYDROGEN SAFETY

With the growing usage of hydrogen comes unique safety challenges. That’s where Fike can assist with the following solutions:
• Process Hazard Analysis
• HAZOP Analysis
• Flame & Gas Detection
• Pressure Relief Solutions
• PRV Leakage Protection
• Explosion Protection

Trust Fike to manage the risks associated with hydrogen and learn more about how we can safeguard your hydrogen applications.


Emissions of mercury from combustion facilities can be reduced by appropriate flue gas cleaning equipment

MERCURY EMISSIONS MONITORING
Bengt Löfstedt from Opsis explains why monitoring of total mercury emissions has become a focus area within the EU waste-to-energy industry, and how the monitoring needs can be met
Historically, mercury (Hg) has found its use in many products such as thermometers, batteries, and fluorescent lamps. However, mercury is extremely toxic and has therefore been banned for use in most applications in recent times. Nevertheless, mercury continues to be released into the environment. Major anthropogenic sources are coal-fired power plants owing to the natural occurrence of mercury in coal, and
waste incineration facilities. In the latter case, the mercury emissions come from old mercury-containing products ending up in the waste being burnt.
Emissions of mercury from combustion facilities can be reduced by appropriate flue gas cleaning equipment. To drive the installation and use of such equipment, legislation can dictate emission limits. A fairly recent example of this is found within the European Union, where the
Industrial Emissions Directive (the ‘IED’) was supplemented by a new set of Associated Emission Levels for waste incineration in 2019. These are referred to as the ‘BAT-AELs’ of the ‘WI-BATC’, where BAT stands for best available techniques and BATC for BAT conclusions. The BAT-AELs became effective in the EU member states end of 2023.
One of the new BAT-AELs states that the total mercury emissions, expressed as a daily average of
The Opsis continuous emissions monitoring system for total mercury
a normalised gaseous mercury concentration in the flue gas, would ideally fall below 5 µg/m3 and in all cases must be kept below 20 µg/m3 The mercury concentration must be monitored continuously unless the waste can be proven to contain a low and stable level of mercury content. Such proof can be hard to obtain, notably in cases of mixed-waste or hazardous-waste incineration.
What then remains is to make sure that the flue gas cleaning equipment is installed and working, and to monitor the remaining mercury emissions continuously. When it comes to the monitoring part, the word ‘total’ in total mercury must be considered. The mercury BAT-AEL applies not only to elementary (metallic) mercury in the flue gas but to all gaseous mercury including compounds such as the relatively commonly occurring mercury chloride (HgCl2) and methylmercury (CH3Hg+). Accordingly, a monitor of total mercury is needed, preferably with a proven reliability and a low total cost of ownership.
The Opsis System 400HG is an example of such a monitoring system. It is based on a technology called differential optical absorption spectroscopy, DOAS. A beam of light is shone through the gas mixture to be monitored. Each type of molecule in the gas gives rise to a specific pattern of light absorption. The more molecules of a given type, the more absorption. By analysing the spectrum of the remaining light, specific gas concentrations can be calculated.
The DOAS method works excellently for elementary mercury (Hg0), where extremely low levels can be detected. This is extended to apply also to total mercury (THg) by introducing a durable catalytic converter. In the complete system, a small amount of flue gas is extracted from the duct and led through the converter. In the converter, all mercury compounds are split up while what already is Hg0 remains unaffected, resulting in mercury only existing as Hg0 after the converter. The gas sample is then led to a monitoring cell where a gas analyser easily detects the Hg0 concentration, and the concentration of total mercury in the flue gas.
The Opsis System 400HG has been thoroughly tested and verified

by the company in harsh industrial environments, and is now being rolled out to customers both within the European Union and elsewhere in the world. The system is QAL1 certified for the measurement ranges 0-10 µg/m3 as well as 0-45 µg/m3
The system has a a supplementary range of 0-100 µg/m3
Operators requiring a complete multi-gas monitoring system can take full advantage of the Opsis monitoring system. A single system can be extended and configured to measure concentrations of many gaseous substances simultaneously, not only
Hg0 and THg but also for example CO, CO2, HCl, HF, NH3, NO, NO2, and SO2. This is applicable to continuous emissions monitoring in many different types of industries as well as to process control needs, for example to control and protect scrubbers and catalytic converters used for flue gas treatment.
Bengt Löfstedt is with Opsis AB, Sweden For more information visit: www.opsis.se
Coal-fired power plants and waste incineration facilities may emit mercury
ADVANCING GREEN HYDROGEN THROUGH INNOVATION
How a sensor that monitors temperature, humidity and location of cells in green hydrogen batteries will advance the green transition
Green hydrogen has been hailed in some quarters as the holy grail of clean energy in the quest for a decarbonised future.
However, it is critical that infrastructure for the production, transportation, storage and use of this power source is firmly in place to fully benefit from its potential.
UK-based engineering company Barnbrook Systems is working with Protium, a leading UK green hydrogen provider, to boost adoption and reduce costs of this renewable fuel.
The company is doing this by supplying its BlueDot remote sensing technology to Protium, which produces and supplies green hydrogen for commercial use, powering fleet, transport trials, construction applications, manufacturing and off grid power –alongside other customer projects.
BlueDot leverages capabilities in remote sensing and the intelligent internet of things (IIoT) via Barnbrook’s BlueCube technology.
HOW DOES BLUECUBE TECHNOLOGY WORK?
The technology fixes BlueDot sensors to cannisters of hydrogen, or cells, in green hydrogen batteries then monitors pressure, meticulously tracking for leaks, as well as safetycritical environmental factors such as temperature, humidity and location. Data is transmitted live into the cloud, enabling reporting to phones, laptops, desktops or smart watches. Alerts can be configured when pressure, temperature or other variables hit certain levels. This supports risk management, emergency response protocols, business continuity and continuous improvement.
With the UK government believing that hydrogen will meet between 20% to 35% of total final energy consumption by 2050, innovative technology of this sort will be crucial to the transition.

CASE STUDY
BlueCube technology is also being used in an E-bag fire suppression system developed with the company’s joint venture partners Flair to extinguish lithium-ion battery blazes in personal electronic devices such as phones and tablets.
Such fires are becoming increasingly common. A house in Norfolk was badly damaged in September 2024 and the M275 in Portsmouth was closed in July after a battery is believed to have caused a major blaze at a waste processing centre.
Innovative nanotechnology has been used to create the E-bag’s temperature sensitive smart fabric which adapts to completely smother a burning battery or device once it has been placed inside.
BlueCube monitors and provides live readings from the interior of the E-bag – including temperature and humidity.
In addition, two major airlines are in talks about E-bag along with businesses in other sectors.
BlueCube is being built into wearable technology, such as personal location beacons for maritime and aviation crew as well as those in safety critical environments.
Barnbrook Systems’ range of Intersonde ultra-high pressure (UHP) transducers have been smart enabled with BlueCube.
They are one of a handful of such systems able to operate and measure pressure with great accuracy at 200,000 PSI (Pressure per Square Inch) or 14 kilobar – greater than that exerted at the deepest point of the ocean.
Robust transducers of this calibre are typically used for nuclear power stations, deep sea exploration, defence, aviation and space – not to mention their potential for hydrogen and renewable energy.
Andrew Barnett is managing director at Barnbrook Systems


Intrusive

ALARP

SafeLane
UXO (Unexploded Ordnance)
EOD (Explosive Ordnance Disposal)
Demining
CONTROL SYSTEMS FOR OFFSHORE WIND
How these HDVC control valves are helping ensure long distance energy transmission with minimal losses
As offshore wind farms expand, the need for efficient and durable control systems is growing. HVDC technology is crucial for integrating renewable energy sources into the power grid, enabling long-distance electricity transmission with minimal losses. HVDC converter platforms are essential for converting direct current (DC) electricity generated by offshore wind turbines into high voltage alternating current (AC) for grid distribution.
Control valve manufacturing specialist Koso Kent Introl won and has delivered a contract to supply control valves for a High Voltage Direct Current (HVDC) converter platform used in offshore wind farms. The contract, secured through a strategic partnership with a prominent offshore transmission system operator, marks an advance for the company itself and ties in with the global push towards sustainable energy.
THE CONTRACT
Koso Kent Introl’s control valves will play a key role in managing fluid flow within HVDC systems, ensuring both operational efficiency and safety. These valves will control the flow of fluids critical to the cooling and operational processes of the converter platform, thereby optimising performance and enhancing system reliability.
To win the contract, the company had to demonstrate its expertise in delivering high-quality, innovative valve solutions across power generation, oil and gas, and water management sectors.
A PARTNERSHIP
The job required collaboration between Koso Kent Introl, the offshore transmission system operator, and the selected international Engineering, Procurement, and Construction (EPC) contractor.

The company’s commitment to sustainable practices aligns with the industry’s shift towards greener energy solutions. It claims to adhere to rigorous environmental standards and actively contribute to reducing the carbon footprint of its customers.
CONTROL VALVES
The control valves used incorporate advancements in fluid dynamics and material science. This innovation is vital for offshore applications, where challenges such as harsh environments, corrosion, and stringent safety regulations are prevalent. That the company also invests in research and development ensures its products meet current standards and are prepared for future industry demands.
The company collaborated with engineers and stakeholders throughout the project lifecycle.
This cooperative approach allows for the custom design and adaptation of control valves to meet specific project needs, enhancing compatibility with diverse system configurations. Such flexibility is essential for the seamless integration of complex offshore wind systems.
LOOKING FORWARD
KOSO Kent Introl argues that as the project progresses, the company will establish itself as a leader in valve manufacturing, it also expects that the successful delivery of control valves for the HVDC converter platform will open significant new opportunities within the expanding offshore wind market.
Koso Kent Introl’s valves play a key role in managing fluid flow within HVDC systems






MAKING WIND FARMS SAFE
Brian Cashion from Firetrace International explores potential safety concerns on windfarms

Fires in wind turbines can lead to catastrophic loss
The importance of wind farms in helping countries to meet their net-zero targets is undeniable, and the number of wind farms now stands at 16,428, according to the latest stats from Global Energy Monitor. However, despite the benefits of wind farms being clear – both from an environmental and commercial point of view – the complexity around green energy systems, such as remote assets, new turbines and co-location of assets, is leading to a greater risk of fire.
Local and central governments are increasingly scrutinising wind farm projects to ensure they meet strict fire safety standards. Countries such as Germany, Australia, France, and South Korea are now mandating that wind developers install fire safety systems on all wind farms. Discussions are ongoing within government offices in other parts of the world, and many believe the momentum for fire safety regulation will continue.
If it does, to avoid falling short of any new fire safety regulations – and to ensure that projects are not delayed or cancelled – engineering teams
should take steps to protect proposed wind farms against fires, therefore alleviating government and local community opposition.
WHY ARE LOCAL COMMUNITIES AND REGULATORS SO CONCERNED?
While statistically the risk of fire at a turbine is low, if it does happen it typically leads to catastrophic loss. This is primarily driven by the fact that wind turbines are tall structures and hard to reach in an emergency. They are also made up of composite materials and maintained using flammable lubricants. In addition, they tend to be running from remote locations where local fire departments may lack the specialist equipment and knowledge to tackle wind farm fires, making it very difficult to tackle fires before it’s too late.
Compounding the challenge further is the rise in new turbine designs that can be untested and unproven and require customised fire suppression systems. The increase in co-located projects - that combine wind and battery, or
solar and battery technologies – has also significantly increased fire risks, as batteries introduce additional complexity and hazards.
HOW CAN ENGINEERING TEAMS PROTECT WIND FARMS AGAINST FIRE RISKS?
While fire suppression may not be a top priority for some developers, there are several relatively straightforward steps that engineering teams can take to alleviate local community and regulatory concerns, especially at the start of a project:
• Discuss fire suppression options with turbine manufacturers
– The majority of wind turbine manufacturers now offer some kind of fire suppression system as an option, but it’s often not part of the standard package. Developers should ask manufacturers what fire suppression options are available to ensure their turbines are protected.
• Pre-install fire suppression systems – If manufacturers do







Brian Cashion, director of engineering, Firetrace

not offer this option, developers should look at pre-installing fire suppression systems. While retrofitting is still a valid and important option, pre-installing is often overlooked and can save developers anywhere between £170k and $253k in downtime loss per farm. It also protects developers against losses of up to £8.5 million in the event of a catastrophic fire.
• Work with local communities from the outset of projects
– Working closely with local communities (especially around permit hearings) as soon as the project kicks off is critical to alleviating concerns about fire safety. This approach will help local citizens, community leaders, and politicians understand the steps that have been taken to minimise risks, such as the presence of highquality fire suppression systems.
• Ensure regular maintenance and site testing – Regular maintenance and site testing helps to reduce fire risks and ensure that safety systems,
Local and central governments are increasingly scrutinising wind farm projects to ensure they meet strict fire safety standards
like fire detection and suppression, are functioning and up to date.
• Understand local fire regulations and conduct comprehensive fire risk site assessments – Taking the time and effort to understand local
fire regulations is one of the most important steps developers can take. Some US states have been slow to adopt the latest fire codes, but developers should make sure they are aware and comply with them from the start. By doing so, they will demonstrate a clear commitment to maintaining the highest standards of fire safety.
Wind farms are a critically important part of the renewable energy transition. Yet, developers are facing greater scrutiny from local communities and regulators over the safety of projects. Failing to pre-install fire suppression systems on wind turbines also means wind energy companies (and the wind sector as a whole) face significant reputational risk. Not recognising these fire safety concerns could significantly hinder growth of the industry and the momentum of the renewable energy transition overall.
International
A SELF-SUFFICIENT PLANT
How plant manufacturer Weltec Biopower helped an Australian wastewater company become energy self sufficient
AGerman plant manufacturer, Weltec Biopower, is helping Yarra Valley Water, one of Australia‘s largest water and wastewater companies. refurbish its 1-megawatt biogas plant in the north of Melbourne. Since the completion of the waste and food waste plant by the plant manufacturer and its project partner in 2017, Yarra Valley Water’s Aurora Treatment Plant has been energy self-sufficient. In order to be able to operate the plant profitably long term, it has been undergoing a technical modernisation including a biological service planned for August.
The output of the plant, which has two 530-kilowatt CHP units, covers the energy requirements of the biogas operation. The electricity generated is able to power both the facility itself and the sewage treatment plant, while excess energy is exported to the electricity grid. The plant has a processing capacity of 33,000 tons of organic waste from food processors and restaurants to generate around 7,500,000 kilowatt hours of energy per year. Accepted waste includes fats, oils, brewery and

dairy residues, as well as fruit and vegetables which are fed into the stainless-steel containers.
PREPARATION FOR WORK
At the start of the maintenance work, the tanks will first be completely emptied. In addition, the roofs of the two 3,573 cubic metre stainless steel fermenters and internal plant components such as the agitator technology will be replaced. The

plant will then be commissioned and operational management will be secured. The digester contents will be temporarily stored in the storage tank and material can be filled back into the tanks after the refurbishment so the plant can be up and running quickly. This saves resources and costs. In addition, it is easier to restart the biological process when the fermented material is immediately available. Last but not least, the processes also comply with occupational safety requirements, which are a high priority in Australia; especially when emptying and filling the tanks. Weltec will also provide onsite staff training.
Stephanie Salinas, manager wasteto-energy services at YVW says of the operation: “Weltec Biopower has been a valued partner in our successful journey with the Wollert Facility. We value its commitment to safety and quality and have leveraged the company’s expertise in mechanical and biological consulting over the lifespan of our facility.”
Yarra Valley Water is one of Australia’s largest water and wastewater companies
The electricity generated is able to power the facility and the treatment plant
APROVIS Energy Systems
Innovative gas and exhaust gas treatment. Since its foundation in 2000, APROVIS has been operating successfully as a medium-sized company on the national and international market. We are constantly developing further.
T +49 9826 / 65 83 – 040
E info@aprovis.com
W www.aprovis.com/en/home-en/

Certas
A premier provider of high-performance lubricants and lubrication solutions and services. Catering to industries including automotive, aerospace, and manufacturing, delivering tailored solutions that enhance equipment performance and operational efficiency.
T 0800 371910
E info@certaslubricants.com
W www.certaslubricantsolutions.com




SafeLane Global Limited
With 30+ years’ experience in demining, explosive and unexploded ordnance disposal, SafeLane Global provides end-to-end consultancy in explosive risk mitigation on land or at sea. Services include: Threat assessments, surveys, investigation, clearance, and ALARP certification.
T +44 1594 368 077
E info@safelaneglobal.com
W www.safelaneglobal.com

Barnbrook Systems
A leading provider of problem-solving innovative solutions for the aerospace, defence, and industrial sectors. Delivering highquality systems and advanced technologies, ensuring reliability and performance across all applications. Partner with us for excellence.
T +44 1329 847722
E sales@barnbrook.co.uk
W www.barnbrooksystems.com

Integrated Global Services (IGS)
Headquartered in Virginia, U.S., IGS is an international provider of surface engineering solutions. It executes projects around the world and has 35+ years of experience helping customers solve metal wastage and reliability problems in mission-critical equipment.
T +1 888 506 2669
E info@integratedglobal.com
W www.integratedglobal.com
OPSIS
OPSIS AB is a globally active manufacturer of innovative systems for air quality monitoring and industrial gas analysis. We provide our customers with reliable and cost-effective measurement systems and services for a wide range of applications.
T +46 46 72 25 00
E info@opsis.se
W www.opsis.se
Rotork
A market-leading global provider of mission-critical flow control solutions for the industrial actuation and flow control markets. We help customers improve efficiency, reduce emissions, minimise their environmental impact and assure safety.
T +44 (0) 1225 733200
E mail@rotork.com
W www.rotork.com


Seal For Life Industries
Seal For Life, part of the Henkel Adhesive Technologies Group, offers the most diversified protection, maintenance and repair solutions in the market. With fourteen distinct brands offering a broad range of products servicing multiple industries across the globe.
T +31 599 696 170
E info@sealforlife.com
W www.sealforlife.com









FUELLING THE FUTURE
A look at several new innovations that promise to open the door to competitively-priced green hydrogen




Hydrogen is well positioned to be the fuel of the future. However, a commercially viable transition to green hydrogen, the environmentally friendly version of the fuel, seems perpetually 10-15 years away. While current processing techniques like electrolysis continue to improve, they still are not able to unlock the potential of green hydrogen for one simple reason: cost.
Hydrogen, the most abundant element in the universe, is an incredibly efficient form of energy that produces zero emissions when burned. Yet, corporations, investors, and even many governments are hesitant to heavily fund technologies that are not cost-competitive with existing alternatives. Fortunately, two notable advancements in green hydrogen processing are promising to close the cost gap.


Hydrogen, the most abundant element in the universe, is an incredibly efficient form of energy that produces zero emissions when burned



These innovations differ from the two most common forms of generating hydrogen today by employing one of the most abundant minerals in the Earth’s crust to unlock low-cost green hydrogen. The developments, which utilise aluminum and water, could enable large-scale operations like power generation plants, along with numerous other applications.
SOMETHING NEEDS TO CHANGE
While there are some common drawbacks with hydrogen – including storage, transportation, and safety –none are viewed as obstacles large enough to deflate hydrogen’s potential as an ideal fuel of the future.
The problem continues to be with the limitations of current production techniques. While hydrogen is abundant, it is almost always found within compounds, like water (H2O) or methane (CH4). Separating hydrogen from methane using steam-methane reforming (SMR), also referred to as blue hydrogen, is by far the most common commercial option and, up until now, the most cost effective. However, a byproduct of the SMR includes carbon dioxide (CO2) which contributes to climate change and can have negative environmental and health impacts. As a result, SMR increasingly requires carbon capture and storage, which increases both the cost and complexity of the production

Electrolysis currently requires an excessive amount of electricity
process, ultimately inflating the final price of the fuel.
Electrolysis, the process of running an electric current through clean, distilled water to separate the hydrogen from oxygen, does not produce byproducts other than hydrogen and oxygen. However, it currently requires an excessive amount of electricity. In fact, according to some studies the process requires about 54 kilowatt hours of electricity (input) to produce just one kilogram of hydrogen – resulting in 33 kilowatt hours of electricity (output).
KICKING THE CAN DOWN THE ROAD
In an effort to move hydrogen forward, MIT recently innovated a clever solution to produce hydrogen with a recipe that essentially consisted of soda cans, seawater, and caffeine.
Documented in a paper published in the journal Cell Reports Physical Science, researchers dropped aluminum pellets, which had been pretreated with a rare-metal alloy, into filtered seawater. The process released hydrogen but at a very slow pace. By adding caffeine, the team was able to significantly speed up the process.
“This is very interesting for maritime applications like boats or underwater vehicles because you wouldn’t have to
carry around seawater — it’s readily available,” said Aly Kombargi, a PhD student in MIT’s Department of Mechanical Engineering.
The team from MIT is working to develop a small reactor that could operate on a marine vessel. This would also alleviate many of the issues with storing and transporting hydrogen.
“We don’t have to carry a tank of hydrogen,” adds Kombargi. “Instead, we would transport aluminium as the ‘fuel,’ and just add water to produce the hydrogen we need.”
While the advancement is noteworthy, a major drawback is that it uses a rare and expensive metal alloy made from gallium and indium.
BUNDLE OF ENERGY
MIT is not the only one innovating with aluminium. Thermodynamics and heat transfer specialist David Sattler and his colleague Robert Fullop have been looking to capture the power of low-cost green hydrogen. Recently, the pair were able to demonstrate a new process that utilises only aluminum, water, and a reusable catalyst.
When mixed using pure aluminum, the three ingredients immediately start a chemical reaction that produces four commercially desirable byproducts: 99.9% pure hydrogen, oxygen, heavy water – which can be used for
fertilizer production, and alumina.
The company’s thermochemical green hydrogen process can also produce fuel when using recycled aluminum. The result is an output of 60% hydrogen. Neither of the clean and recycled processes require electricity and both can utilise purified water as well as water sourced directly from oceans, rivers, lakes or grey wastewater to produce hydrogen.
ENERGISING EARTH
If the cost of green hydrogen can be significantly reined in using the methods described or something similar, the element’s impact could be felt immediately. It might be put to use in co-fired coal power generation plants or within today’s internal combustion engines (ICE).
With the Infrastructure Act of 2021, the US Congress appropriated $8 billion to support hydrogen projects, signaling a commitment to a hydrogen-powered future and its intention to lead the world in the transition. The challenge now is to improve hydrogen processing techniques to drive down costs.

DANGEROUS WATERS


A guide to mitigating the issue of unexploded ordnance
The oceans have long been used as dumping grounds for surplus munitions, particularly after World Wars I and II. These munitions or UXO (unexploded ordnance), including both conventional explosives and chemical warfare agents, were disposed of in vast quantities. As they corrode, they leak hazardous chemicals into the marine environment, posing significant risks to ecosystems and human health. This largely unknown crisis demands attention owing to its widespread implications for marine life and the food chain.
The volume of UXO dumped into oceans globally is staggering. Millions of tons of conventional and chemical UXO have been discarded across various sites, including the Baltic Sea, Arctic Ocean, North Sea, Japanese and the United States coastal waters. For instance, Norway (Skagerrak Strait), has around 168,000 tons of dumped chemical weapons. Russia’s Arctic seas contain approximately 150,000 tons of munitions, while Japan’s waters hold around 5,000 tons. These figures represent a fraction of the total, with


some estimates suggesting over 127 documented dump sites worldwide, and many more likely remaining undocumented.
TOXIC CHEMICALS RELEASED
UXO submerged in the ocean is not inert and over time, exposure to seawater causes the metal casings to corrode, releasing toxic chemicals into the surrounding environment. These munitions contain hazardous explosive materials such as TNT, RDX, mustard gas, and sarin, as well as heavy metals like mercury, lead and arsenic. As they degrade, these chemicals leak into the ocean, contaminating the water and posing a significant threat to both marine ecosystems and human populations.
The rate of corrosion is influenced by factors such as water temperature, salinity, depth and case thickness. Warmer waters accelerate the process, causing munitions to leak hazardous substances more quickly. Moreover, as munitions degrade, they can become more prone to spontaneous detonation, posing risks to both marine life and
A particularly concerning issue is bioaccumulation, where toxins build up in the tissues of marine organisms over time

human activities.
The breakdown of munitions can create harmful byproducts. For example, TNT degrades into even more toxic substances, such as ADNT and DNT, which have carcinogenic and genotoxic effects. These chemicals are absorbed by marine organisms, entering the food chain and causing harm to animals and humans alike.
The leakage of toxic chemicals from corroding munitions severely impacts marine ecosystems. These chemicals contaminate large areas of the ocean floor, making these environments uninhabitable for many species. Toxins affect organisms at every level of the food chain, from small filter feeders like mussels to larger predatory fish and marine mammals.
THE ISSUE OF BIOACCUMULATION
A particularly concerning issue is bioaccumulation, where toxins build up in the tissues of marine organisms over time. Mussels, oysters, and other filter feeders living near munitions dump sites can absorb large amounts of toxic chemicals, rendering them






Clean Energy Safety Solutions
—
Supporting a Safer Journey to Net Zero
Dräger, with a legacy spanning over 100 years, is your trusted safety partner in this journey
We deliver comprehensive safety solutions tailored for the evolving clean tech landscape. From gas detection and respiratory protection to service and rental, we’re dedicated to protecting your team and assets in the face of new challenges across various sectors — be it hydrogen, carbon capture, battery production, offshore wind, waste-to-energy, or nuclear We are not just a supplier; we are a partner in your journey towards a safe and sustainable future.






The dumping of munitions into the oceans has left behind a toxic legacy that threatens both marine life and human health
unsafe for human consumption. Fish exposed to these substances may suffer from reproductive issues, developmental abnormalities, and increased mortality rates. Studies have found that fish living near chemical munitions dump sites, such as cod in the Baltic Sea, often show signs of weakened immune systems and physiological stress, which negatively impacts their populations.
Marine mammals like dolphins and whales are also at risk and can suffer physical injuries from underwater explosions, damaging their hearing, a critical sense for navigation and communication. Such disruptions can lead to behavioural issues, stranding, or even death.
Oceanic munitions dumping also poses serious health risks to humans. One of the most pressing concerns is contamination of seafood. Consuming seafood from areas near munitions dump sites exposes humans to carcinogens, neurotoxins, and heavy metals. Long-term exposure
to these substances can lead to a variety of health problems, including cancer, neurological disorders, and developmental impairments, particularly in children.
Heavy metals such as arsenic, lead, and mercury are particularly dangerous. These substances can damage the kidneys, brain, and other organs. In communities where seafood is a primary food source, the risks are significantly higher, as people may consume contaminated fish regularly. Coastal populations that rely on fishing for both food and livelihood are especially vulnerable.
There have also been documented cases of fishing boats and crew suffering injuries and equipment damage following unintentional interactions with UXO.
The dumping of munitions into the oceans has left behind a toxic legacy that threatens both marine life and human health. Coordinated global efforts are needed to address this environmental disaster and prevent
future generations from suffering its devastating consequences.
HELP FROM SAFELANE
SafeLane Global is an end-to-end consultancy service that mitigates these dangers and negative ecological impacts of the chemical and explosive risks. Using the hierarchy of risk management, SafeLane is able to mitigate these risks with techniques such as risk assessments, surveys and disposal methods. By completing these operations, SafeLane aims to reduce the detriments of UXO to subsea environments in addition to protecting subsea assets.
This editorial is a synthesis of existing information and SafeLane owned information. As such, please contact SafeLane Global for relevant references and citations.
For more information visit: www.safelaneglobal.com


AN ALTERNATIVE
FUEL

Exploring regulation and safety when using ammonia and methanol to fuel the maritime Industry


From December 2nd to December 6th 2024, the International Maritime Organisation’s (IMO)
Carriage of Cargoes and Containers subcommittee is expected to approve interim guidelines for using ammonia as an alternative fuel. These guidelines advise that ammonia be stored and refrigerated at atmospheric pressure. They also propose detection thresholds at 25 ppm in enclosed spaces, 110 ppm in secondary enclosures, and 220 ppm to trigger alarms and shutdowns. Additionally, ships should install ammonia treatment systems to manage potential leaks.
However, these interim guidelines for ammonia and other existing interim guidelines for other alternative fuels are still considered too broad by experts, as they cover only basic functional requirements and do not address the practical, real-world handling of the chemicals. For the industry to effectively and safely transition to ammonia or other alternative fuels like methanol, more detailed guidance from industry leaders with experience in detecting and preventing safety incidents with these substances is essential.
MANAGING SIMILARLY CHALLENGING PROPERTIES
Ammonia and methanol have their own particular safety challenges. For example, exposure to ammonia vapours can cause irritation and damage to the eyes, nose, throat, and lungs. In higher concentrations, ammonia can be fatal. Methanol is also toxic. It affects several organs as well as the central nervous system, which can lead to long-term damage or death. Methanol is readily absorbed by all routes of exposure, including the skin.
In addition, both molecules are flammable. Ammonia can be ignited between 14 Vol.-% (lower explosion limit, LEL) and 32.5 Vol.% (upper explosion limit, UEL). Spontaneous ignition occurs at 630°C in the presence of sufficient oxygen. Methanol is a highly flammable gas and can be ignited at concentrations between 6 Vol.-% (LEL) and 50 Vol.-% (UEL). Spontaneous ignition occurs at 440°C, making the threshold lower than it is for ammonia.
On top of that, both substances have unique dispersible behaviours that are challenging for tight
environments like ships. Ammonia is typically lighter than air. However, humid conditions can lead to the formation of ammonia vapour. This vapour is heavier than air, causing it to sink. Methanol is slightly denser than air (32 versus 28 grams per mole). The vapour often follows the movement of air. But if methanol is warmer than the surrounding air, it will rise. If it is cooler, it sinks and accumulates near the ground.
These are just some of the properties to consider when looking at future regulations for safe handling of these hazmats in maritime environments. To ensure the safety of workers, the environment and property, by addressing these special safety challenges, appropriate protective systems must be planned and implemented, such as gas and flame detectors as well as personal protective equipment (PPE).
POSSIBLE DETECTION SOLUTIONS ON SHIPS
With its decades of experience, Dräger, a leader in gas detection, offers point gas detection as one tried and true method for sensing gas leaks. This technology focuses
New guidelines for using ammonia in maritime operations are expected imminently
on identifying gas presence at a specific location, requiring the gas to come into contact with the sensor to be detected. Such an approach is particularly effective in enclosed areas where gases are likely to gather. A leading solution in this field is the Dräger Polytron 8100 EC. This device is capable of identifying over 100 types of toxic gas and ensures continuous monitoring, even in extreme conditions such as high moisture levels and temperature fluctuations ranging from -40°C to +65°C. It comes with an integrated memory that stores all calibration and configuration data, allowing the sensor to be pre-calibrated and ready to use immediately upon installation.
Fire detection represents a further crucial layer of safety in maritime operations. The engine room, a critical area laden with continuous supplies of oxygen, heat, and fuel, is particularly susceptible to fire threats. This is because these elements collectively create ideal conditions for fires to ignite and propagate. Modern flame detection uses infrared sensors to identify hydrocarbon-based fires from a distance. For instance, the Dräger Flame 1500 (IR3) operates by

measuring infrared radiation across three different wavelengths. These measurements are then compared to reference values of CO2, a byproduct of hydrocarbon combustion. This technology enables early detection of fires, thereby mitigating the potential for severe damage.
While handling methanol and ammonia, proper PPE is another

The Dräger Polytron 8100 EC is capable of identifying over 100 types of toxic gas
necessary safety measure. During transport, refills or transfers, leaks or errors can lead to the escape of these toxic chemicals. That’s when respiratory protection can be life saving. Whether ammonia or methanol is the molecule in question will also determine if any further PPE is needed. Safety leaders recommend filtering devices like half masks with ammonia whereas methanol due to its characteristics might require independent air-supplying units.
INVOLVING EXPERTS
As the shipping industry explores methanol, ammonia and also hydrogen as alternative fuels, the technology remains in its early stages, presenting numerous challenges that must be addressed to ensure a safe transition. Upcoming guidelines will provide a framework for integrating alternative fuels into the industry. However, it is crucial to consult with industry experts like Dräger who have experience with these chemicals and implement systems to detect them.
Drawing on their insights will help build a robust base of knowledge, guiding the industry on how to effectively retrofit existing vessels or design new ships that leverage these future-oriented fuel options.
Exposure to ammonia can cause damage to the eyes, ears, nose, throat and lungs
OFFSHORE WIND NORTH EAST EXPLORING OPPORTUNITIES
Offshore Wind North East (OWNE), to take place on Wednesday 6th of November, is a leading event exploring themes and opportunities in the offshore wind sector for the north east of England.
The region has been developing capabilities in offshore wind since 2000, using its experience and expertise in other industries to diversify and create a vibrant offshore wind supply chain. It is now a leader in the the green energy revolution, playing a key role in energy security and the UK journey to net-zero 2050. The industry has contributed significantly to the creation of new jobs, economic growth and the regeneration of coastal communities.

The infrastructure includes six highly-active ports, with windfarms including Dogger Bank and the Sofia Offshore Wind Farm.
The show boasts an array of speakers who will update the conference on their business activities, opportunities for the supply chain and

how to engage with the sector. An opening session features Joanne Leng MBE, CEO of NOF with subsequent speakers representing companies such as PDL Solutions, Port Training Services, RWE and Equinor. There will be approximately 900 attendees, 130 exhibitors and 30 speakers at the event. Delegates will be able to attend the full two-day conference, and receive a complimentary lunch and refreshments, access to all presentations and an invite to a networking drinks reception.









EUROPEAN HYDROGEN WEEK
THE FAST TRACK TO THE FUTURE
That hydrogen will come to play a central role in the energy transition is widely accepted, and so the strapline for European Hydrogen Week, ‘the fast track to the future’, will not surprise anyone. The show, to take place in Brussels, Belgium, between the 18th and 22nd November will focus on every aspect of the hydrogen economy.
An increasing number of companies and investors are prioritising hydrogen. Yet, every
business decision carries a risk and to mitigate them connections and knowledge-sharing are key. This event aims to provide a space for powerful and influential leaders, policy makers, researchers, and end users to discuss how to develop their hydrogen transition. Companies can expect to find customers, investors and partners in the exhibition area as well as be able to attend thoughtprovoking conferences. Attendance to the expo area and the B2B Forum
is unlimited for all participants, however seats for the High-Level Policy Conference are limited owing to the auditorium restrictions.
Free public transport cards will be issued to all attendees for use on the metro, bus or tram. Registration for the event is now open.




6 - 7 Nov Sunderland, NE England
A national event in a pioneering offshore wind region of the UK
900+ Delegates
130+ Exhibitors












